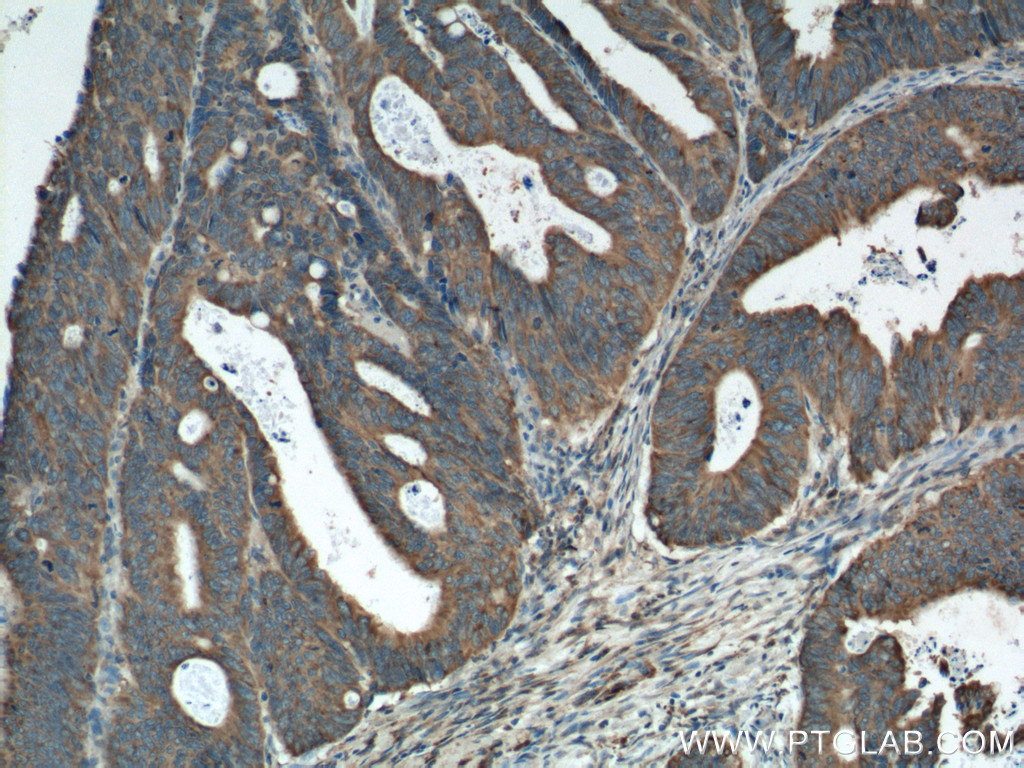

验证数据展示
经过测试的应用
| Positive WB detected in | A549 cells, MCF-7 cells, Calu-1 cells, HepG2 cells, L02 cells |
| Positive IP detected in | HepG2 cells |
| Positive IHC detected in | human stomach cancer tissue, human colon tissue, human colon cancer tissue Note: suggested antigen retrieval with TE buffer pH 9.0; (*) Alternatively, antigen retrieval may be performed with citrate buffer pH 6.0 |
| Positive IF-P detected in | human colon cancer tissue, mouse embryo tissue, human placenta tissue |
| Positive IF/ICC detected in | HeLa cells, HepG2 cells |
| Positive FC (Intra) detected in | HeLa cells |
推荐稀释比
| 应用 | 推荐稀释比 |
|---|---|
| Western Blot (WB) | WB : 1:1000-1:4000 |
| Immunoprecipitation (IP) | IP : 0.5-4.0 ug for 1.0-3.0 mg of total protein lysate |
| Immunohistochemistry (IHC) | IHC : 1:50-1:500 |
| Immunofluorescence (IF)-P | IF-P : 1:50-1:500 |
| Immunofluorescence (IF)/ICC | IF/ICC : 1:50-1:500 |
| Flow Cytometry (FC) (INTRA) | FC (INTRA) : 0.20 ug per 10^6 cells in a 100 µl suspension |
| It is recommended that this reagent should be titrated in each testing system to obtain optimal results. | |
| Sample-dependent, Check data in validation data gallery. | |
产品信息
16036-1-AP targets Amphiregulin in WB, IHC, IF/ICC, IF-P, FC (Intra), IP, ELISA applications and shows reactivity with human, mouse samples.
| 经测试应用 | WB, IHC, IF/ICC, IF-P, FC (Intra), IP, ELISA Application Description |
| 文献引用应用 | WB, IHC, IF, IP |
| 经测试反应性 | human, mouse |
| 文献引用反应性 | human, mouse, rat |
| 免疫原 |
CatNo: Ag8907 Product name: Recombinant human AREG protein Source: e coli.-derived, PGEX-4T Tag: GST Domain: 25-252 aa of BC009799 Sequence: AGLDLNDTYSGKREPFSGDHSADGFEVTSRSEMSSGSEISPVSEMPSSSEPSSGADYDYSEEYDNEPQIPGYIVDDSVRVEQVVKPPQNKTESENTSDKPKRKKKGGKNGKNRRNRKKKNPCNAEFQNFCIHGECKYIEHLEAVTCKCQQEYFGERCGEKSMKTHSMIDSSLSKIALAAIAAFMSAVILTAVAVITVQLRRQYVRKYEGEAEERKKLRQENGNVHAIA 种属同源性预测 |
| 宿主/亚型 | Rabbit / IgG |
| 抗体类别 | Polyclonal |
| 产品类型 | Antibody |
| 全称 | amphiregulin |
| 别名 | AREG, AR, AREGB, Colorectum cell-derived growth factor, CRDGF |
| 计算分子量 | 252 aa, 28 kDa |
| 观测分子量 | 43 kDa |
| GenBank蛋白编号 | BC009799 |
| 基因名称 | Amphiregulin/AREG |
| Gene ID (NCBI) | 374 |
| RRID | AB_2227602 |
| 偶联类型 | Unconjugated |
| 形式 | Liquid |
| 纯化方式 | Antigen affinity purification |
| UNIPROT ID | P15514 |
| 储存缓冲液 | PBS with 0.02% sodium azide and 50% glycerol, pH 7.3. |
| 储存条件 | Store at -20°C. Stable for one year after shipment. Aliquoting is unnecessary for -20oC storage. |
背景介绍
Amphiregulin (AREG) is one of the ligands of the epidermal growth factor receptor (EGFR). AREG plays a central role in mammary gland development and branching morphogenesis in organs and is expressed both in physiological and in cancerous tissues. The AREG protein is synthesized as a 252-amino acid transmembrane precursor, pro-AREG. At the plasma membrane, pro-AREG is subjected to sequential proteolytic cleavages within its ectodomain and is then released as the soluble AREG protein. Depending on the cell type and microenvironment, AREG can be produced in multiple cellular and mature forms using alternative pro-AREG cleavage sites and glycosylation motifs. Post-translastional modfications of 50-kDa pro-AREG produces a major soluble 43-kDa form, 28-, 26-, 16-kDa membrane anchored forms, and soluble 21-, 19-, and 9-kDa forms (PMID: 9642297).
实验方案
| Product Specific Protocols | |
|---|---|
| FC protocol for Amphiregulin antibody 16036-1-AP | Download protocol |
| IF protocol for Amphiregulin antibody 16036-1-AP | Download protocol |
| IHC protocol for Amphiregulin antibody 16036-1-AP | Download protocol |
| IP protocol for Amphiregulin antibody 16036-1-AP | Download protocol |
| WB protocol for Amphiregulin antibody 16036-1-AP | Download protocol |
| Standard Protocols | |
|---|---|
| Click here to view our Standard Protocols |
发表文章
| Species | Application | Title |
|---|---|---|
Proc Natl Acad Sci U S A AhR controls redox homeostasis and shapes the tumor microenvironment in BRCA1-associated breast cancer. | ||
Cell Commun Signal BMAL1 ameliorates type 2 diabetes-induced cognitive impairment via AREG upregulation and PI3K/Akt/GSK-3β pathway activation | ||
Cell Biosci TPM2 attenuates progression of prostate cancer by blocking PDLIM7-mediated nuclear translocation of YAP1 | ||
Aging Cell Targeting amphiregulin (AREG) derived from senescent stromal cells diminishes cancer resistance and averts programmed cell death 1 ligand (PD-L1)-mediated immunosuppression.
|